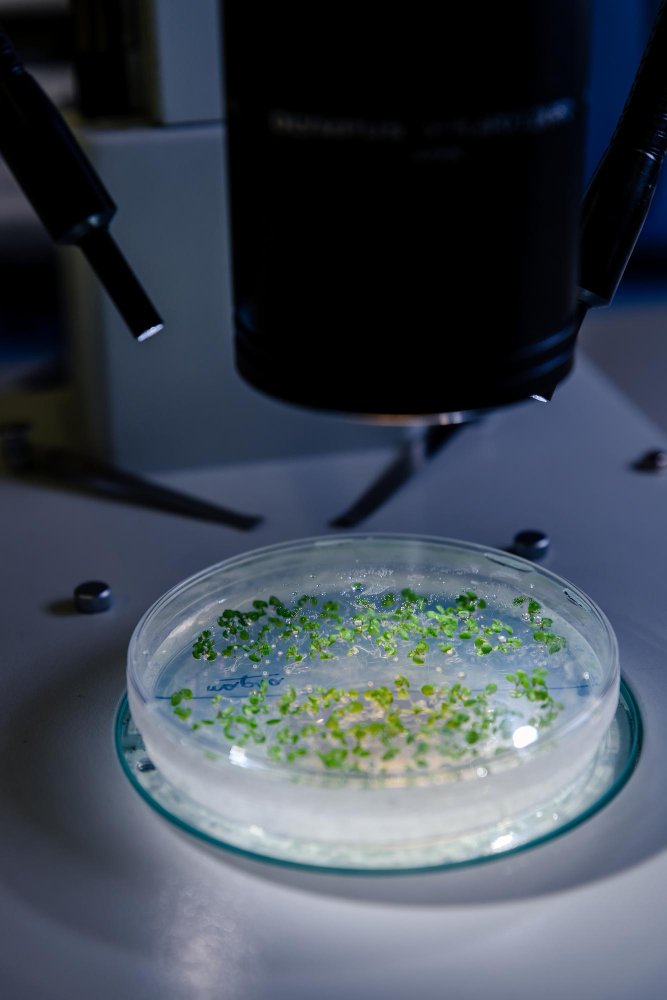

Chemicals
- Home
- Services
- Chemicals



Chemicals
Eram Asacon offers an extensive range of high-quality chemical products tailored to meet the dynamic needs of industries across the globe. With a focus on safety, innovation, and sustainability, their chemical solutions are engineered to deliver exceptional performance and reliability. From industrial-grade chemicals to specialized formulations, Eram Asacon ensures strict adherence to global standards, guaranteeing efficiency and compliance in every application.

Microsilica
Download Our
Catalogue And Profile
Explore our services and expertise, download catalogue and profile.
Get In Touch
We’re here to help! Contact us for inquiries, support, or product information. Our team is ready to assist and ensure you get the best experience. Reach out anytime!